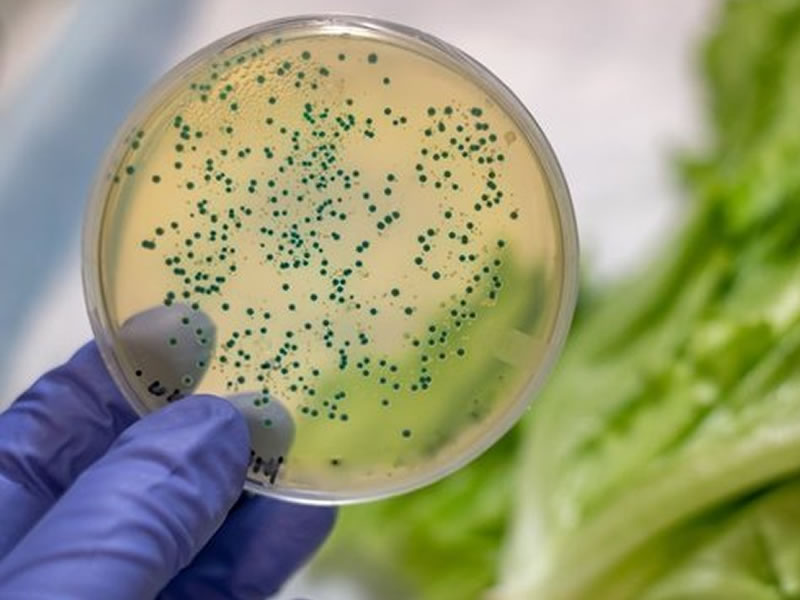
/17875saude2101.jpg

Editoria Saúde

A cápsula inteligente que aplica insulina sem causar dor
Colunista fala de experimento americano que traz uma solução irreverente pa...

Por que o corpo incha mais no calor?
Nos dias de muito calor, o corpo precisa trabalhar para não superaquecer e ...

Asma: pesquisadores encontram origem do problema
Ausência de uma molécula no organismo estaria relacionada ao surgimento da ...

Infecção por dengue pode proteger contra o zika
Estudo brasileiro sugere que pessoas que já foram infectadas pela dengue te...

Um leite específico para os sensíveis ao produto?
Surge no mercado uma linha da bebida e de seus derivados com potencial para...

Repelentes naturais e soluções caseiras para afastar mosquitos funcionam?
Repelentes à base de plantas e outras medidas alternativas são comuns aqui....

Exames periódicos evitam mortes por câncer de mama, diz estudo
O rastreamento populacional de mulheres para fazer o diagnóstico precoce do...

Comer inseto faz bem ao intestino, mostra estudo
Em pesquisa, farelo de grilo contribuiu para a proliferação de bactérias bo...

Estresse pode ser passado de pai para filho
Estudo aponta que momentos de tensão durante a vida dos homens repercutem a...

O avanço de 2019 para o câncer – e 9 prioridades da ciência para tratá-lo
Entidade dos Estados Unidos aponta os progressos frente a tumores raros com...

Surdez ´seletiva´? A rara doença que faz com que as pessoas parem de escutar vozes masculinas
Caso registrado na China de mulher que não conseguia ouvir o namorado nem f...

Remédio moderno para artrite reumatoide será oferecido pelo SUS
Esse medicamento, além de ser oral, possui a mesma eficácia dos chamados tr...

O primeiro banho do bebê: é melhor esperar em nome da amamentação?
Nosso colunista parte de um conselho divulgado na internet e colocado à pro...

Quais são os sintomas do zika na gravidez?
O zika vírus tem preocupado as gestantes devido às possíveis complicações q...

Bactérias na boca: quando elas viram um perigo
Profissional explica em que situações esses micro-organismos causam problem...

Caixa de leite com quadrados coloridos significa que ele foi reprocessado?
Vídeo que circula na internet alerta sobre suposto excesso de substâncias q...

Remédio anestésico pode virar tratamento contra a depressão resistente
O fármaco teria ação antidepressiva potente até em casos que não respondem ...

Ansiedade, estresse e cansaço aumentam o risco de Alzheimer
Estudo revela que sofrimento emocional constante estaria relacionado a uma ...

Castrar gatas previne o câncer de mama
O terceiro tumor mais comum em gatas pode ser evitado com a castração. Saib...
Biossensor brasileiro avisa se alimentos estão contaminados por bactérias como a salmonella
Inovação desenvolvida no interior de São Paulo pode ser solução mais barata...
Nós usamos cookies e outras tecnologias semelhantes para melhorar a sua experiência em nossos serviços, personalizar publicidade e recomendar conteúdo de seu interesse. Ao utilizar nossos serviços, você concorda com tal monitoramento. Informamos ainda que atualizamos nossa


